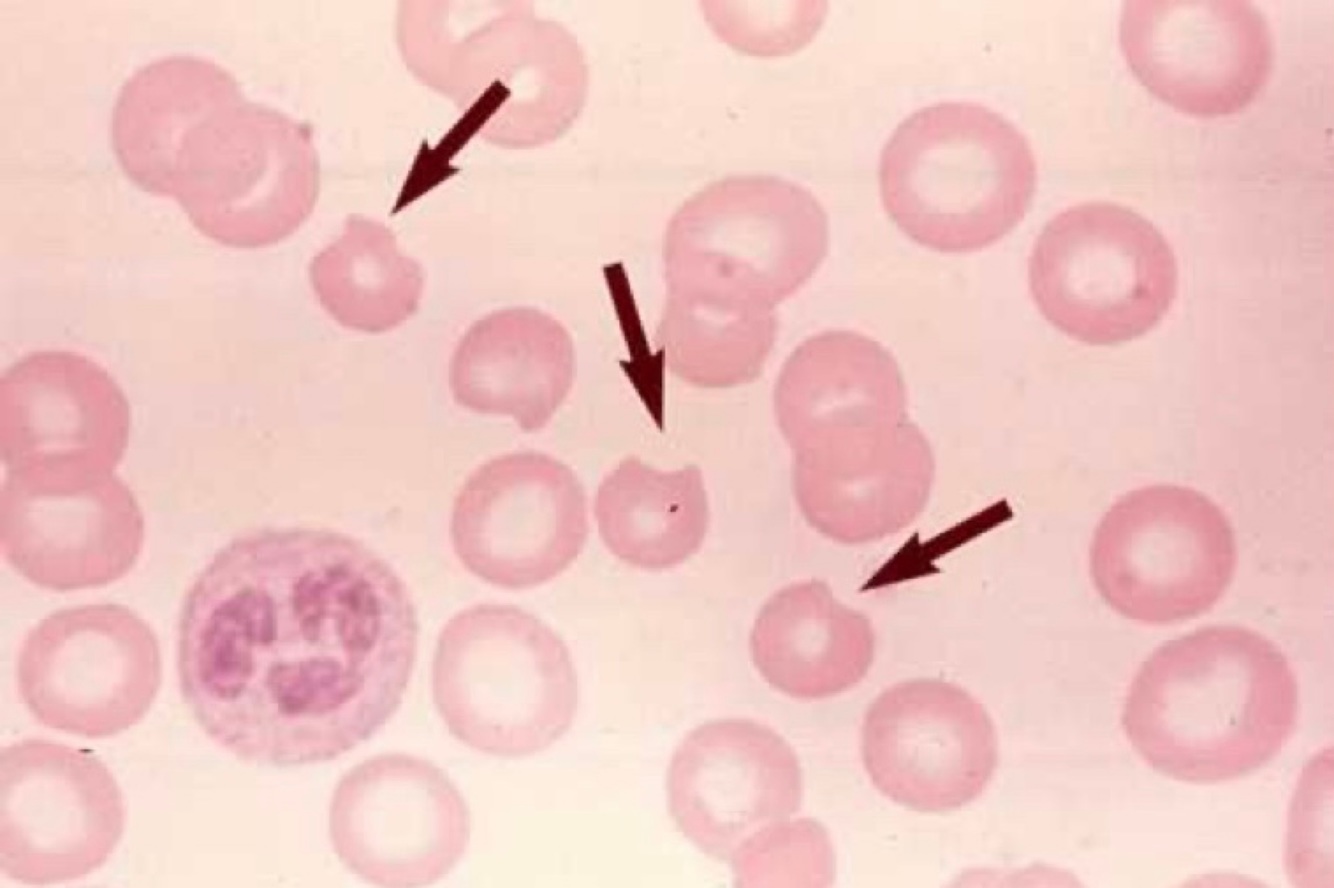
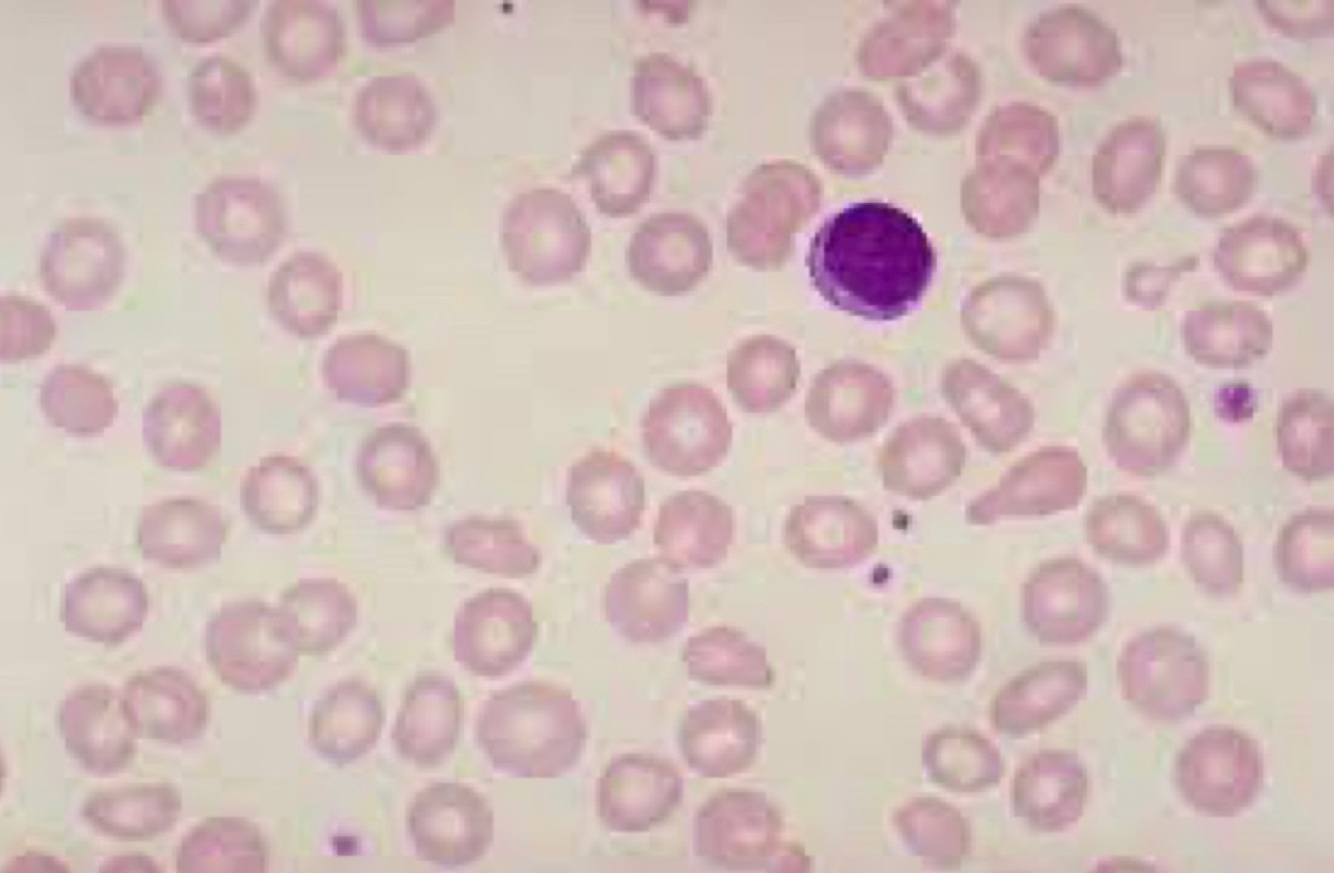
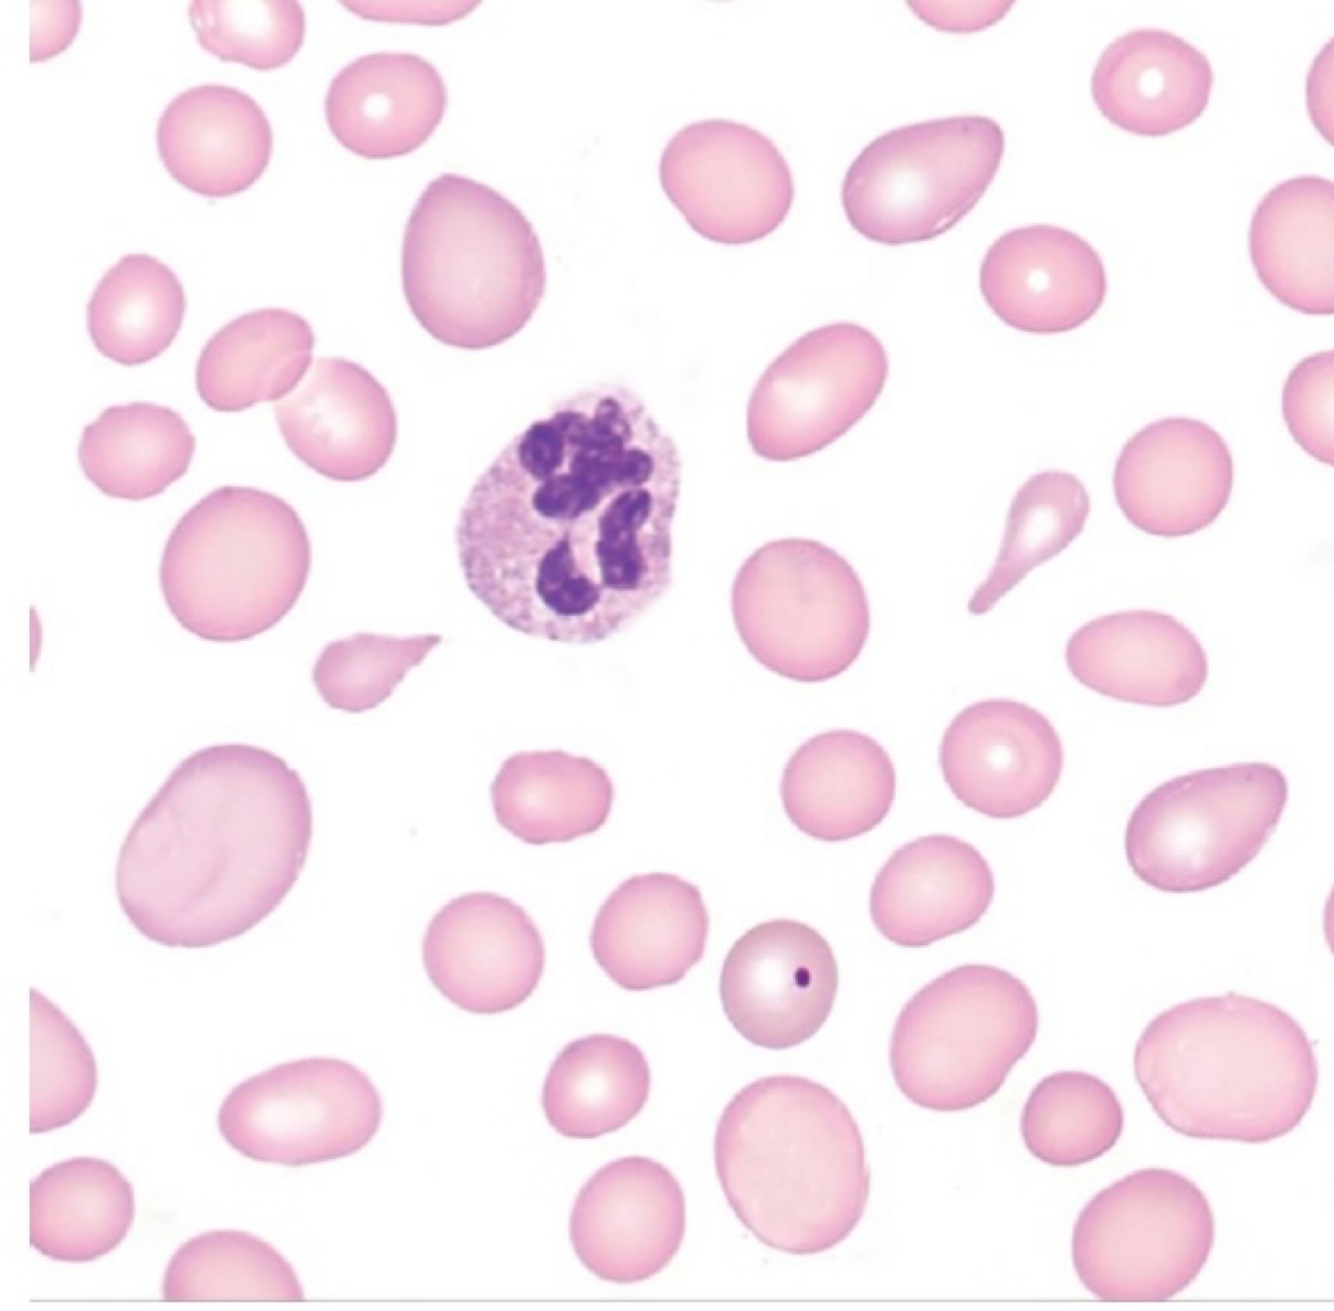
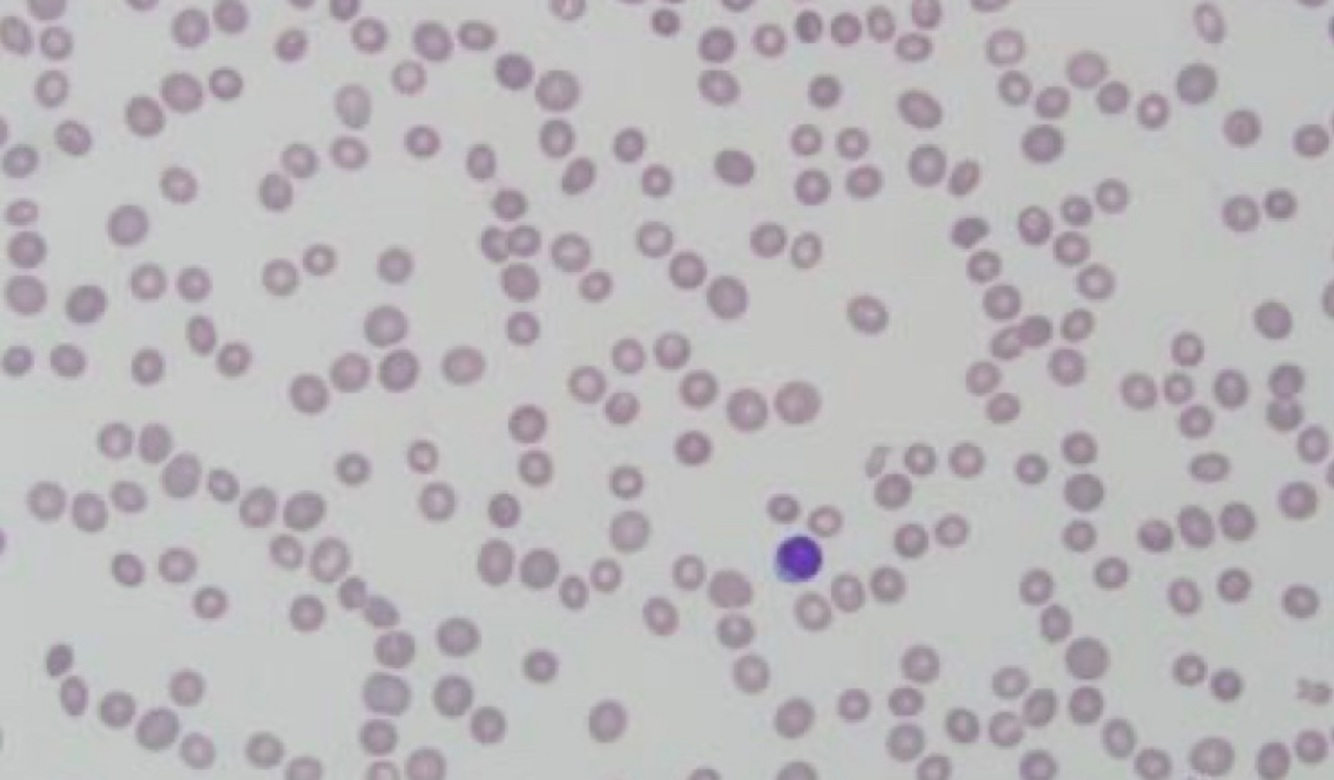
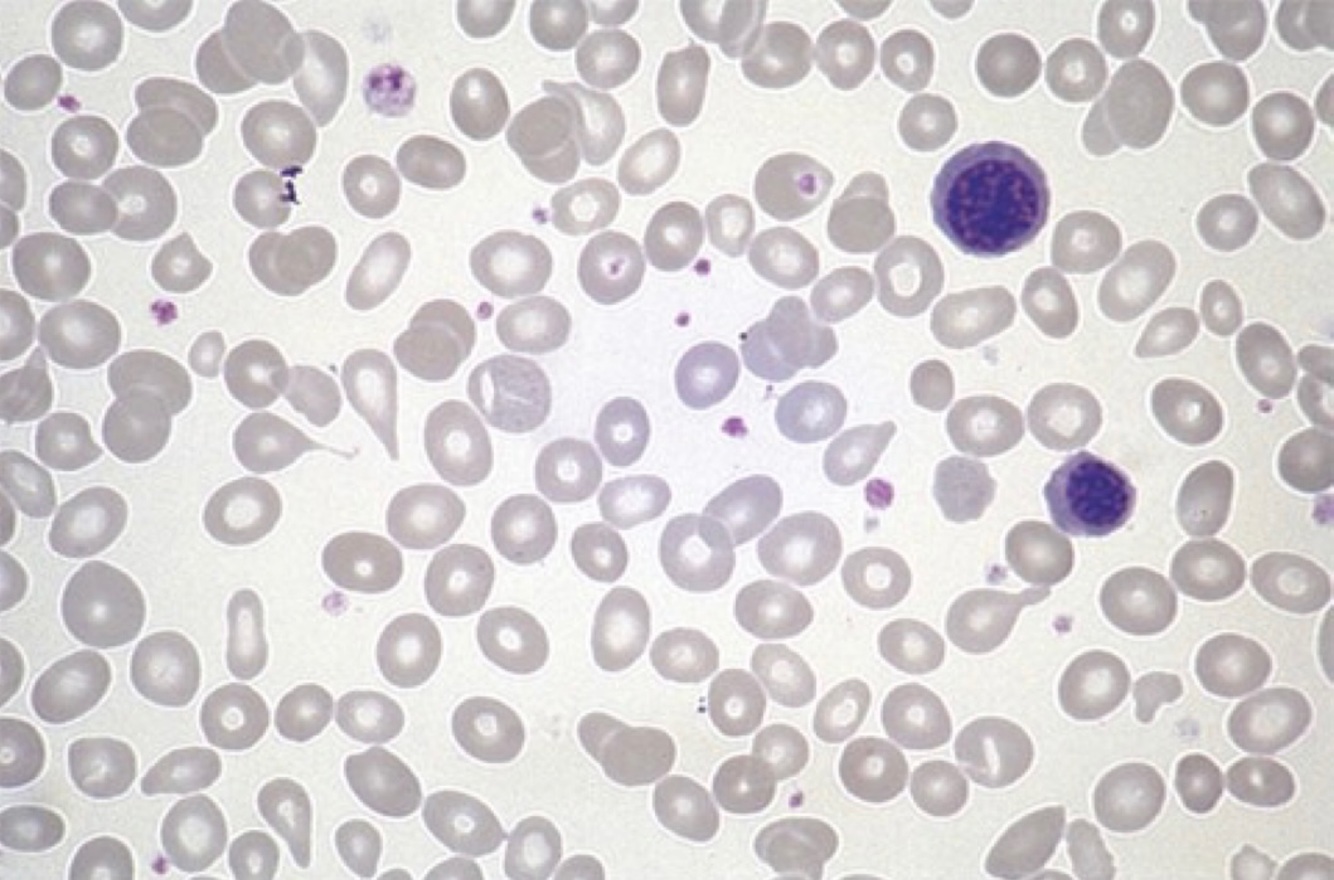

What does MCV mean and what does it reflect? What is the formula? What is the normal range?
Mean red blood cell volume reflects RBC diameter (volume)
Hematocrit/rbc count x 10
80-100fL
What does MCH mean and what does it reflect? What is the formula? What is the normal range?
Mean corpuscular hemoglobin reflects weight of hemoglobin in the average red blood cell
Hemoglobin/RBC count x 10
26-34 pg
What does MCHC mean? What is the formula? What is the normal range?
Mean cell hemoglobin concentration
Hemoglobin/hematocrit x 100
32-36 g/dL
What does RDW mean and what does it reflect? What is the normal range?
RBC distribution width reflects the degree of volume variation
12-14.5
What is the normal range of hematocrit and how is it calculated
Normal range: 40-52% for males and 35-47% for females
RBC/total volume x 100
Formula for calculating % retics
Number of retics/1000 RBC x 100
Formula for calculating retic index corrected? When does it get used/corrected?
% Retics x hematocrit/hematocrit of 45 (M) or 42 (F)
Gets used to adjust for the level of anemia to obtain a more accurate reflection of erythropoiesis
Calculation for reticulocyte production index (RPI)
Retic index (corrected)/maturation time (aka how old the sample is)
What is the RPI when bone marrow is not responding
RPI < 3
What is the RPI when bone marrow is responding
RPI > 3
How to calculate hemocytometer
Cell count x dilution factor/volume (1x1x0.1) = cells/mL
How to do a WBC estimation
Count WBCs for 10 fields at 40x
Divide by 10 to find average
Multiply by 2,000
ex: 2.5 x 2000 = 5.0x10^3/microliter
How to do a platelet estimation
Count platelets in 10 fields at 100x
Divide by 10 to find average
Multiply by 20,000
Ex: 10 x 20,000 = 200x10^3/microliter
What is the mentzer index and how is it calculated
A calculation used to differentiate between IDA and thalassemia
MCV/RBC
What does it mean if your mentzer index is greater than 13
Low RBC = IDA
What does it mean if your mentzer index is less than 13
High/increase RBC = thalassemia
How do you do a manual diff
Count 100 WBCs differentiating each kind
Name the disease and what to look for
G6PD deficiency
Degmacytes “bite cell”
Polychromasia
Heinz bodies (supravital stain)
Normocytic, normochromic
Name the disease and what to look for
Iron deficiency anemia (IDA)
Microcytic, hypochromic
Low ferritin
High transferrin
High TIBC
Low transferrin saturation %
High thrombocytosis
Name the disease and what to look for

Anemia of chronic disease
Microcytic, hypochromic
High ferritin
Low transferrin
Low TIBC
Low transferrin saturation %
Common in lupus, renal disease, etc.
Name the disease and what to look for

Sideroblastic anemia
Microcytic, hypochromic
Iron satellites
Pappenheimer bodies
Basophilic stippling
Acquired: lead poisoning
High ferritin
Low transferrin
Low TIBC
High transferrin saturation %
Name the disease and what to look for
Megaloblastic anemia
Hypersegmented neutrophils
Ovalocytes
Macrocytic
High/normal iron, ferritin, transferrin saturation %
Elevated homocysteine (B12 breaks down homocysteine)
Could also have poikilocytosis or anisocytosis
Pancytopenia observed
B-12 = elevated methylmalonic acid (MMA)
Can’t absorb B12
Name the disease and what to look for
Aplastic anemia
Pancytopenia (decreased all cells)
70% idiopathic
Hypocellular BM
Liver enzymes elevated
Increase serum iron
Increase transferrin saturation
Acquired: pregnancy, drug therapy, viruses (parvovirus b19/HIV)
Name the disease and what to look for
Myelophthistic anemia
Usually caused by cancer
Dacryocytes! And nRBCS




















